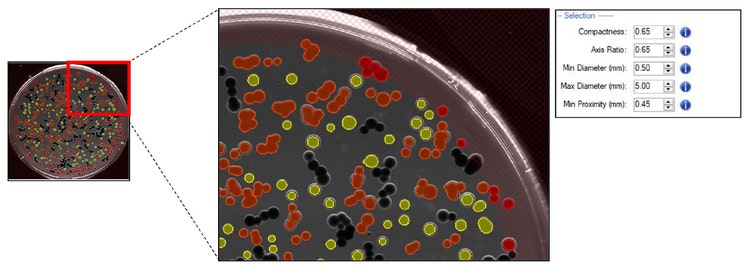
Pickable colonies are displayed in yellow
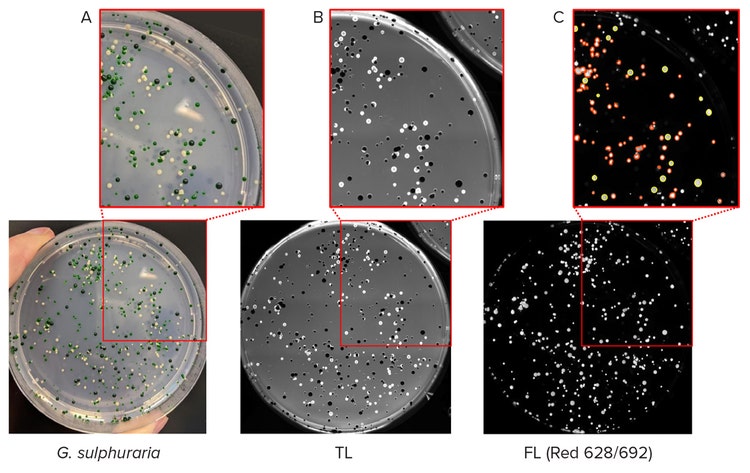
high-expressing C-phycocyanin colonies

Application Note
Leveraging microalgae metabolism to produce natural food dyes: an automated screening approach
- Quantitative fluorescent screening enables efficient and objective selection of unique clones
- Maintain subsequent clonal integrity during bio-production
- A variety of fluorescent filter sets increases experimental flexibility
- Easy-to-use software ensures the right colony is picked every time based on the defined experimental parameters
Carola Mancini | Application Scientist | Molecular Devices
Audrey S. Commault, Rodrigo Rangel, Julien Demol | Fermentalg
Introduction
Microalgae & food Industry
Microalgae are photosynthetic organisms growing in water systems, which convert atmospheric CO2 to organic molecules such as carbohydrates, lipids, and other bioactive compounds. Due to these biological properties, microalgae represent a renewable and sustainable source of food ingredients, including animal-free omega-3, alternative proteins and natural pigments used in the food and beverage segment.
The potential of microalgae to meet dietary needs has drawn the attention of the food industry. According to the European Food Safety Authority (EFSA), natural food pigment demand is increasing among consumers who prefer natural products over potentially toxic synthetic food additives1. However, natural pigments might be sensitive to light exposure and can change colour when exposed to different environmental conditions (pH and temperature); in addition, they are generally available in a limited colour range. All these factors motivate the R&D around new natural pigments to be used as food dyes. The discovery of microalgal pigments with interesting properties for the food industry requires high throughput automation to screen a large number of microalgal strains in a reduced time. With this technology, Fermentalg® laboratories have leveraged Galdieria sulphuraria metabolism to produce a natural blue pigment rich in C-phycocyanin extracted and commercialized as BLUE ORIGINS®2.
BLUE ORIGINS® is a natural pigment with properties such as stability at low pH and high temperatures compared to other microalgae-derived dyes, making it suitable for a wide range of applications in food and beverage industry, such as candies, beverages, and ready-to-eat cereals. To date, C-phycocyanin is the only blue pigment in the FDA food colouring agent exempt product list, making it suitable for the manufacturing of natural products.3
Fermentalg® scientists have developed innovative methods to screen and select microalgal strains using the QPix 420 microbial colony picker (Molecular Devices®). Traditionally, colony picking is performed manually using sterile pipette tips or inoculation loops which are usually slow, labour-intensive, and time-consuming. QPix 420 system allows for high throughput colony picking with more than 3,000 colonies picked in an hour and >98% picking efficiency. A variety of fluorescent filter sets increase system flexibility and walk-up operations, enabling phenotypic selection of unique colonies based on morphological features and levels of fluorescent protein expression or fluorescent pigments.
Materials and methods
In the search for a strain of Galdieria sulphuraria producing high levels of C-phycocyanin, Fermentalg® has obtained and preserved a set of variants with different C-phycocyanin contents. The strains were plated on Gross-agar medium4 (pH 3) and incubated for two weeks at 37°C with 60% humidity in the dark. All plates were imaged and analysed with the QPix 420 system, which allows for fast walk-up operations. Compatibility with different microorganisms is ensured by the use of appropriate pin type; in this case, christmas tree-shaped pins were utilized to successfully pick and inoculate G. sulphuraria colonies. Sterility was maintained by the use of three wash baths to sanitize pins (Fig. 1).

Figure 1. Colony screening workflow with QPix 420 system
Results
A fluorescent approach to screen G. sulphuraria colonies
A fluorescence-based approach to select colonies of the microalgae Galdieria sulphuraria was used. This organism is rich in C-phycocyanin, a water-soluble protein found in bluegreen algae which gives them their characteristic bright blue colour. When excited with a red light, C-phycocyanin emits fluorescence with a peak at 642 nm5.
Two weeks old colonies of G. sulphuraria were imaged and screened under transmitted light and fluorescence on the QPix 420 system, which enables objective identification and selection of colonies producing the fluorescent pigment of interest (C-phycocyanin in this case). At first, a test image of the plate under transmitted light and the selected fluorescence is acquired by QPix Fusion Software (Fig. 2 A and B, respectively). The test images can be adjusted by defining the acquisition settings, including exposure time. Visualization of detected colonies is displayed by a green overlay created by the software algorithm in correspondence with every detected feature.

Figure 2. (A) Test image in transmitted light of the microalgae G. sulphuraria. QPix Fusion Software™ shows detected features creating a green overlay on each colony. (B) Test image of the same sample was acquired in fluorescence channel (Ex/Em filter: 628/692nm) to detect colonies expressing C-phycocyanin.
Once images are captured, the QPix Fusion Software analyses them based on the feature properties and identifies the location of individual colonies on the culture plate (Petri plate, Omnitray or QTray). Fusion software flexibility allows the user to define the desired colonies based on morphology such as colony size, compactness, axis ratio, diameter, and minimum proximity. Selected colonies of G. sulphuraria were therefore included (Fig. 3, yellow) or excluded (Fig. 3, orange) based on the selection criteria.
Figure 3. Pickable colonies are displayed in yellow. Orange: colonies excluded according to selection criteria. Top right panel: selection criteria defined for accurate colony picking.
Quantitative, tuneable fluorescence intensity threshold specifies the desirable level of protein expression. To select cells containing the highest concentrations of C-phycocyanin, the range of fluorescence needs to be adjusted. For this experiment, colonies producing C-phycocyanin with a Mean Fluorescence Intensity (MFI) value between 36000 and 43000 were selected (Fig. 4 A and B, respectively). Once selected based on userdefined criteria, colonies were accurately picked with QPix 420 system.

Figure 4. Fluorescent screening of G. sulphuraria colonies producing C-phycocyanin. (A) Representative fluorescent image of G.sulphuraria colonies expressing different levels of C-phycocyanin. The Red filter pair (Ex/Em: 628/692) was used. (B) Fluorescence histogram displayed as Mean Intensity
Screening and detection of high-expressing C-phycocyanin colonies
Finally, different G. sulphuraria strains producing varying concentrations of C-phycocyanin were analysed using the QPix 420 system to test the ability of the equipment to discriminate and select the high-expressing C-phycocyanin colonies, which visually appear as dark green-coloured (Fig. 5 A). As expected, colonies with the lowest concentration of C-phycocyanin appeared white on agar-plates, while colonies expressing average levels of the pigment appeared light green. The different strains were therefore imaged in transmitted light with the QPix 420 and then screened based on C-phycocyanin fluorescent emission (Fig.5 B-C). A fluorescent signal for the dark green- and light green-colored colonies was detected. In particular, dark green colonies were successfully selected and picked based on the previously tested Mean Fluorescence Intensity values ranging from 36000 to 43000. Lastly, the disappearance of the white colonies in fluorescent imaging confirmed the absence of C-phycocyanin in this microalgae population.
Figure 5. Selection of high-expressing C-phycocyanin colonies. (A) Colonies of G. sulphuraria with different pigmentation were analysed. (B) Transmitted light (TL) image of the same plate of colonies detected with QPix 420 camera. (C) Fluorescent image (Red filter pair, Ex/Em: 628/692nm) of G. sulphuraria colonies. Pickable colonies are displayed in yellow. Orange: colonies excluded according to selection criteria.
Summary
The food industry interest in microalgae is rising due to the increased demand for natural and sustainable food ingredients. Fermentalg® is leveraging microalgae metabolism to develop and screen multiple G. sulphuraria strains producing a low pH and high temperature-stable natural blue pigment as food ingredient (BLUE ORIGINS®). To accelerate this product to the industry, automated colony screening of G. sulphuraria colonies was performed. High throughput colony picking offers significant advantages over conventional screening methods, including faster identification of desired clones which streamlines the subsequent downstream analysis. QPix 420 fluorescence capabilities were used to select clones producing the highest concentrations of C-phycocyanin, therefore accelerating the scale up of microalgae-based natural pigment production. In summary, high throughput automation holds a great promise for the future development of microalgal products.
References
- Carocho M, et al. Adding Molecules to Food, Pros and Cons: A Review on Synthetic and Natural Food Additives. Compr Rev Food Sci Food Saf. 2014 Jul;13(4):377-399. doi: 10.1111/1541-4337.12065. PMID: 33412697
- Athane et al., The safety evaluation of phycocyanin-enriched Galdieria sulphuraria extract using 90-day toxicity study in rats and in vitro genotoxicity studies. Toxicology Research and Application 2020.
- Minxi Wan et al., Comparison of C-phycocyanin from extremophilic Galdieria sulphuraria and Spirulina platensis on stability and antioxidant capacity, Algal Research 2021, Volume 58.
- Gross, W. & Schnarrenberger, C. (1995): Heterotrophic growth of two strains of the acido-thermophilic red alga Galdieria sulphuraria. Plant Cell Physiol. 36(4): 633-638.
- Niels T. Eriksen, Production of phycocyanin—a pigment with applications in biology, biotechnology, foods and medicine. Applied Microbiology and Biotechnology, 2008.